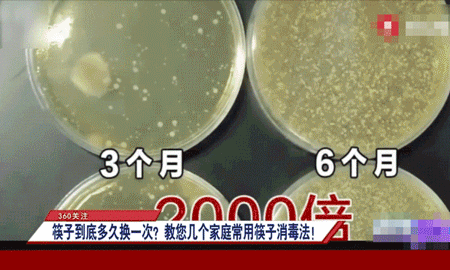

中国作为美食大国,用筷子3000多年,一口饭一口菜,一年四季,都离不开它。
从小时候爸妈手把手教着使用筷子,到成年时摆好碗筷等孩子回家吃饭,它每天陪伴着我们,既是传承也是温情。

但就是这么重要的筷子,很多的家庭,却压根不去重视它。
都是能不换就不换、发霉了也继续用、哪个便宜买哪个……

不然立刻检查一下,你家的筷子是不是:
竹筷、木筷;
凹槽、裂痕;
黑点、发霉、潮湿!

千万别觉得这也无所谓,事实上,有裂缝、霉点的筷子比你想象得要脏的多。
政法频道报道过,使用3个月的木筷在显微镜头下,密密麻麻的细菌在蠕动,比厕所马桶还要脏。

这些细菌里不光是普通有害菌,还可能包含了幽门杆菌、黄曲霉菌。

幽门杆菌是胃病的“元凶”,更是被美国列为明确致癌物,传染性非常强。

黄曲霉菌的毒性比砒霜大68倍,是目前已知最强的致癌物之一。
即使沸水煮上20-30分钟,也不能完全杀死。想想这样脏的筷子,怎么放心给家里孩子用。

所以我们对待筷子、餐饮卫生要格外留心,做好生活中的细节,无形中就是在保护自己还有家人的健康。
❌每个月更换筷子,费钱又麻烦;
❌不锈钢筷虽然不像木筷会潮湿、有裂缝,但是会有电解质析出,产生毒性。
最好的选择,还是这款不潮湿不变形、不吸水不吸油、用上三五年都跟新买一样的——
客满多日式不发霉合金筷👇👇👇

它几乎摒弃了市面上筷子的所有缺点,合金材质不开裂、不发霉,水轻轻一冲就干净,从源头杜绝藏污纳垢。

还引进日本银离子抗菌技术,抑菌率高达99.9%!用它吃饭,每一餐都能吃的安全卫生。

一套共有5个颜色,方便好区分,刚好帮助家里人养成“专人专筷”的好习惯,避免幽门杆菌、感冒、病毒等交叉感染。
关键颜值还超高,设计师手绘小鱼图案,寓意「年年有余」「好运爆棚」。

正好年底了,给家里换上一副安全卫生、趁手又高颜值的筷子,看着就心情愉悦,热热闹闹过个好年~
强烈推荐理由
1、客满多专研合金筷,不吸水不吸油不发霉,拒绝藏污纳垢;
2、引进日本银离子抗菌技术,抑菌率高达99.9%,每餐都吃得安全放心;
3、原创小鱼图案设计,寓意年年有余,多种颜色方便专人专筷!
不潮湿、不裂缝
拒绝藏污纳垢的健康筷
使用合金筷1年与使用木筷3个月的对比:
合金筷干干净净,没有任何缝隙、黑点,跟刚买来一样;而超市普通的木筷,已经开始有凹槽裂缝,长出绿色霉点,一摸还潮乎乎的。

差别之所以这么大,是因为这款日式合金筷采用高分子PET材料和玻璃纤维合成,硬度强、韧性高,还具备木筷所没有的高密度和不可吸附性。

暴力揉搓、使劲掰、180度高温消毒,都不会出现断裂和变形,藏污纳垢更是不可能的事。
这可不是在空口吹牛,来看我们的实验:
一根筷子提起一桶水,轻轻松松,甚至都没怎么弯,完全不担心家里小孩调皮会摔坏筷子;

100度沸水煮15分钟后立刻拿出来掰,用大力也掰不断,平时可以放心扔进消毒柜消毒。

煮了这么久也没有掉漆,不担心漆、蜡会吃进嘴里。

而且不吸水,不吸油。
普通筷子一沾水,立刻就渗进去了,就算外面擦干了里面依然是潮湿的,很容易生霉菌。

而合金筷水珠一沾到就掉落,里、外都是干爽的,哪怕南方遇上雨季都不担心生出细菌。

酱油沾上去,也是一擦就擦干净,没有残留。

平时吃完饭,油腻、菜汁一冲即净,不放洗洁精都没事,简直不要太方便。

而且合金筷中还添加AG+银离子的微量元素,只要有细菌出现在筷子上,就会被银离子刺破外膜,最终失去活性死亡。

无裂缝、好清洗、好晾干,细菌根本没有生长的条件,这样的筷子才是让家长都安心的「健康筷」。
有粉丝买回家用了3个月反馈,之前家里的木筷很快就长斑点了,而合金筷怎么用都跟刚买来的一样,好清洗、好打理,家里孩子都爱用它。

有质感、防打滑
小孩也能夹得稳稳当当
跟很多木筷、不锈钢筷不同,合金筷拿起来非常有质感,有分量感但不重,用着刚刚好。


筷身有防滑纹理,手上有油水也不容易打滑,放在桌上也不会滚落下去。

筷尾有磨砂纹理设计,好夹取饭菜,刚学会用筷子的宝宝也能稳稳夹起一块肉。

我们进行了难度超高的夹豆子测试,滑溜溜的豆子,一夹一个准,超稳当。

饺子、馄饨、蛋都能轻松夹起来,再也不担心汤汁溅得满桌都是。

用它吃饭夹菜,你会真正体会到什么叫“得心应手”!
设计师原创手绘图案
养成“专人专筷”好习惯
一袋日式合金筷里共有5双筷子,5种颜色:海棠红、清水蓝、赤茶橘、军草绿。
正好方便一家人进行颜色区分,专人专筷,在疫情还未散去的当下,连专家都很提倡这种用餐方式。

还能很好地避免幽门杆菌、感冒等病毒的交叉感染,防止一人生病,全家生病。
筷头印有很漂亮的小鱼图案,这是客满多专门邀请设计师原创手绘而成,独此一家,别无分店。

当你拿着小鱼图案的筷子吃饭,寓意「年年有余」,一年「从头顺到尾」,好运大吉。
在这个新年将至的时候,这样一双筷子真的祝愿满满,心意独特。

每天拿着这么颜值高、又有质感的筷子吃饭,心情都好了不少,原本不爱吃饭的宝宝都举手多来一碗!让妈妈省不少心~

客满多开山鼻祖
合金筷只认这一家
这款合金筷的生产厂家非常厉害,它来自客满多,专业的餐具生产有限公司。
他们家光筷子的专利就有46项,砧板20项,这可都是其它品牌做梦都拿不下的荣誉。


合金筷最早是由客满多董事长方春生亲自开发并命名,一经上市就凭借着优质的原材、抗菌性能、超高颜值俘获了顾客的芳心。
到目前为止,市面上50%以上的合金筷都是客满多的,你去商场吃饭,几乎店里的筷子都是它们家的。

在业内权威的中国日用百货商品交易会上,客满多展区挤满了参观的人,来自40多个国家的专业买家连连好评。

每一双合金筷,都在2万多平方米的生产车间生产,生产资质和质量保证都符合国家行业标准。
很多顾客用过合金筷后,都大呼「相见恨晚」,把把家里的筷子都换成了它。

用3年还跟新买的一样
性价比超高
这双合金筷质量好、颜值高、寓意美好,自用送礼都合适。
送老人,寓意平安喜乐,福气临门;

送朋友,寓意年年有余,百事顺意;

自己用,厨房焕然一新,颜色明亮,生活美好。

平时去超市买木筷、竹筷,便宜的20多块,其实顶多用一两个月,就得换新了,算下来一点也不划算。

而这款合金筷,买一次用3年还是新的,价格也贵不了多少:
原价69元/5双,公众号购买,价格给大家谈下来了:5双39.9元就能入手!
10双减15,15双送5双(相当于买3送1),多买几双备用更划算!
花点小钱就能给家人更好的保护,想想都觉得太值啦,过年了也正好换换门面,美滋滋~

写下你的想法